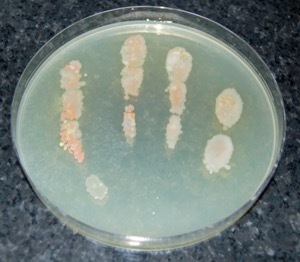
Microorganisms on the fingers of an unwashed hand.
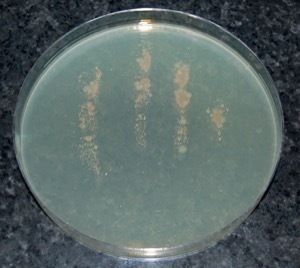
Microorganisms on the fingers of a hand washed in warm soapy water.

In Summary
- The following shows a demonstration of the important of handwashing in reducing microbial contamination on hands. Particularly when using soap and water, then alcohol based hand sanitisers.
The importance of effective handwashing in the control of cross-contamination
If the fingers of an unwashed human hand are pressed into a non-selective agar plate which supports the growth of microorganisms, and the plate is incubated at 25oC for 48 hours.

Then typically, results similar to the picture shown on the left are observed.
Unwashed human hands harbour a wide variety of surface microorganisms. Some of these organisms could be human pathogens with the potential to cause an outbreak of foodborne illness.
In order to reduce as much as possible a worker's hands transferring contamination to food; it is necessary to wash the hands of workers who touch food as frequently as possible.
If only warm water is used when washing hands, a small and insignificant reduction in the numbers of microorganisms on the skin surface is typically observed as shown in the picture on the left.
Washing hands in plain tap water is not a very effective way of controlling skin surface microorganisms in food processing establishments.
The benefits of using liquid soap and warm water are shown in the picture on the left.

Compared with an unwashed hand there is a significant reduction in skin-surface microorganisms when washing in warm soapy water.
Soaps are detergents and they tend to act by removing the oil from the surface of human skin that microorganisms live in. In addition, soap can directly dissolve the membranes that form the outer layer of some bacteria directly causing their deaths.
In the picture on the left, the areas occupied by the white bacteria have diminished compared with the pictures above indicating that soap has reduced the viability of the white bacteria.
In contrast, the reddish coloured microorganisms appear largely unaffected by the soap.
When an alcohol gel is used to sanitise a hand after washing in warm soapy water, it is difficult to recover many microorganisms from the skin surface (Monaghan and Hutchison, 2016).
In combination, hands properly and frequently washed in warm soapy water which are then sanitised with an alcohol gel can adequately control the contamination of foods from the hands of workers.
